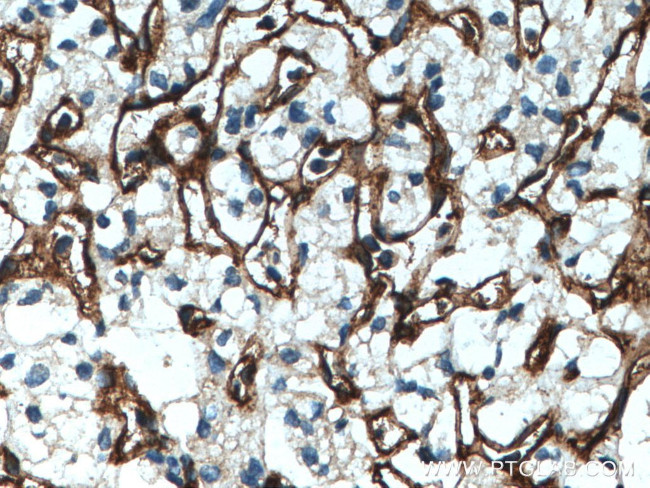
Endoglin/CD105 Antibody in Immunohistochemistry (Paraffin) (IHC (P))
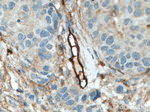
Endoglin/CD105 Antibody in Immunohistochemistry (Paraffin) (IHC (P))
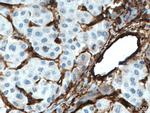
Endoglin/CD105 Antibody in Immunohistochemistry (Paraffin) (IHC (P))

Search
Proteintech
Endoglin/CD105 Polyclonal Antibody
{{$productOrderCtrl.translations['antibody.pdp.commerceCard.promotion.promotions']}}
{{$productOrderCtrl.translations['antibody.pdp.commerceCard.promotion.viewpromo']}}
{{$productOrderCtrl.translations['antibody.pdp.commerceCard.promotion.promocode']}}: {{promo.promoCode}} {{promo.promoTitle}} {{promo.promoDescription}}. {{$productOrderCtrl.translations['antibody.pdp.commerceCard.promotion.learnmore']}}
产品信息
28117-1-AP
种属反应
宿主/亚型
分类
类型
抗原
偶联物
形式
浓度
规格
纯化类型
保存液
内含物
保存条件
运输条件
产品详细信息
Immunogen sequence: QPVGPERGE VTYTTSQVSK GCVAQAPNAI LEVHVLFLEF PTGPSQLELT LQASKQNGTW PREVLLVLSV NSSVFLHLQA LGIPLHLAYN SSLVTFQEPP GVNTTELPSF PKTQILEWAA ERGPITSAAE LNDPQSILLR LGQAQGSLSF CMLEASQDMG RTLEWRPRTP ALVRGCHLEG VAGHKEAHIL (33-221 aa encoded by BC014271 )
靶标信息
CD105 or Endoglin is a Type I transmembrane protein, which is highly expressed on human vascular endothelial cells. It exists on an O- and N-glycosylated homodimer. Up regulation of endoglin expression has been demonstrated in tumor vasculature and proliferating cells, suggesting that it is a proliferation associated endothelial marker. CD105 binds to TGF beta 1 and 3 with high affinity but not to TGF beta 2.
仅用于科研。不用于诊断过程。未经明确授权不得转售。
生物信息学
蛋白别名: CD105; CD105 antigen; circulating isoform of endoglin TGF-beta receptor type III; Endoglin; endoglin precursor; ORW; soluble endoglin; unnamed protein product
基因别名: END; ENG; HHT1; ORW1
UniProt ID: (Human) P17813
Entrez Gene ID: (Human) 2022